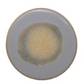

Stoneware Trivet, Reactive Glaze, 12 Colors
Stoneware Trivet, Reactive Glaze, 12 Colors
Regular price
$7.00 USD
Regular price
Sale price
$7.00 USD
Unit price
per
Shipping calculated at checkout.
Couldn't load pickup availability
4-1/4" Round Stoneware Trivet, Reactive Glaze, 12 Colors (Each One Will Vary)







-
Returns
Returns within 30 Days with original tags and digital receipt are good for store credit. See Refund Policy for more details.